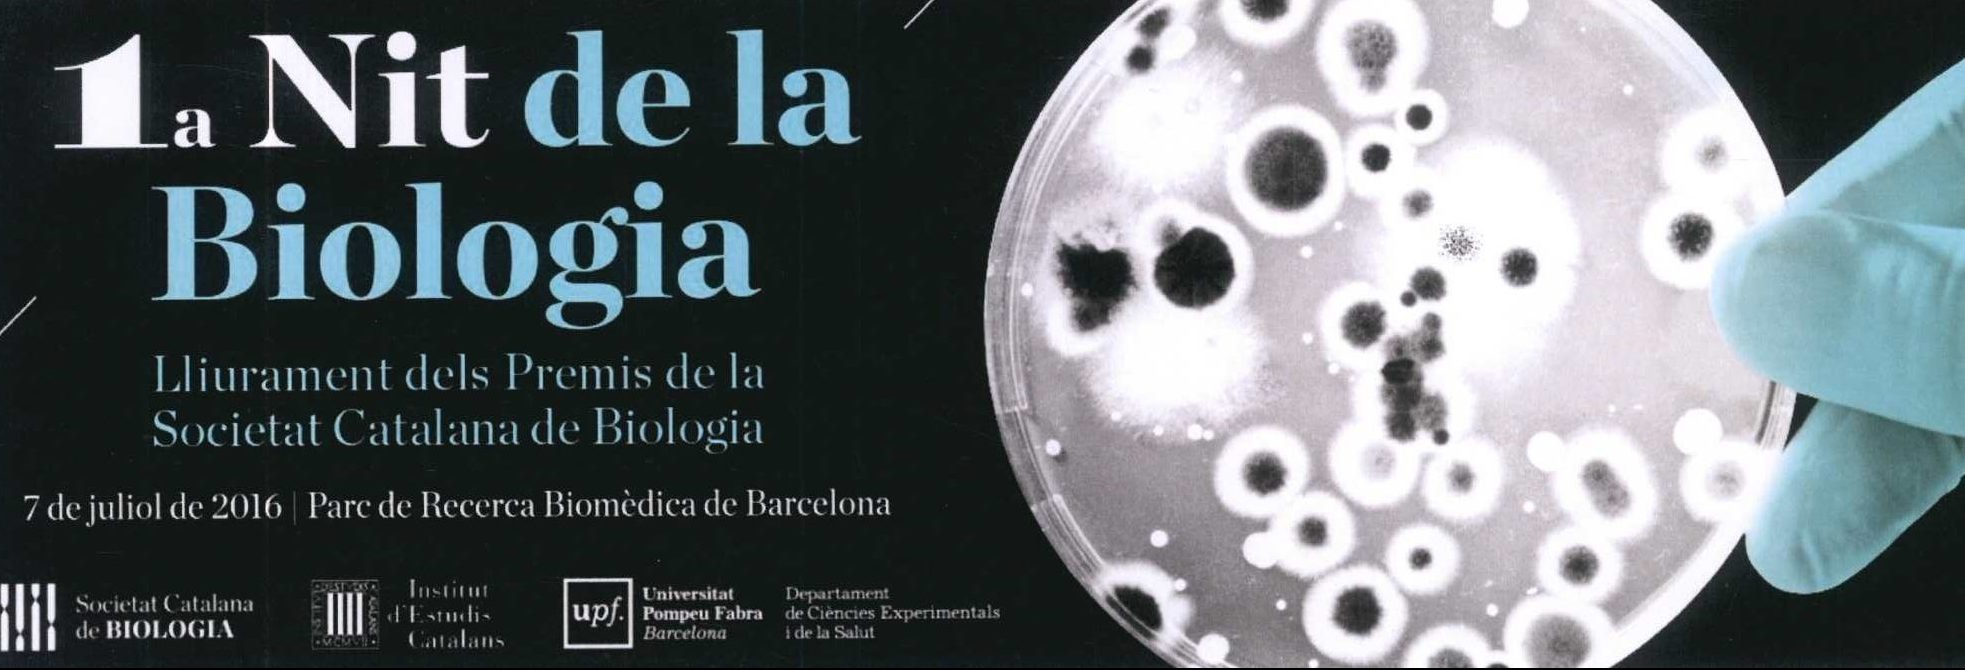

Francesc Sardà – Per què la crisi no acabarà mai? – 25/01/2017
Llibre: Per què la crisi no acabarà mai? Xerrada-debat: Per què la crisi no acabarà mai? Avui dia 25 de gener de 2017, en el marc de la 10a edició de les Tertúlies de Literatura [...]
David González Jara – Nuestros aliados microscópicos – 20/12/2016
Llibre: Bacterias, bichos y otros amigos Xerrada-debat: Nuestros aliados microscópicos Avui dia 20 de desembre de 2016, en el marc de la 10a edició de les Tertúlies de Literatura Científica (TLC) a la Facultat de [...]
Josep M. Casacuberta – El genoma fluid – 14/12/2016
Llibre: El genoma fluid Xerrada – debat: El genoma fluid Avui dia 14 de desembre de 2016, en el marc de la 10a edició de les Tertúlies de Literatura Científica a la Facultat de Ciències i Tecnologia [...]
EXPOSICIÓ: La Història de la vida
Us convidem a poder visitar l’exposició que durant aquest curs 2016/17 els estudiants de 3r curs de Grau en Biologia, de la UVic-UCC, a l’assignatura d’Evolució, han realitzat, amb el vist-i-plau de la professora Mireia Bartrons que imparteix [...]
Juli Peretó – Lynn Margulis: la teoria endosimbiòtica – 23/11/2016
Llibre: Simbiosis: seres que evolucionan juntos Xerrada-debat: Lynn Margulis, la teoria endosimbiòtica Avui 23 de novembre de 2016, en el marc de la 10a edició de les Tertúlies de Literatura Científica a la Facultat de Ciències [...]
Elena Sancho – Tecnologia Crispr/Cas9 – 26/10/2016
Dossier: Tecnologia Crispr/Cas9 Xerrada-debat: Tecnologia Crispr/Cas9 Avui 26 d’octubre de 2016, en el marc del Projecte de les Tertúlies de Literatura Científica a la Facultat de Ciències i Tecnologia de la Universitat de Vic-Universitat Central de [...]
Manel Esteller – Epigenètica – Epigenoma – 06/10/2016
Llibre: Aposta per la salut! Pensant en el futur, raons per ser optimista. Xerrada-debat: Epigenètica – Epigenoma. En el marc de les Tertúlies de Literatura Científica que cada any organitza la Facultat de Ciències i [...]
Jordi Domènech Casal – Llegir a les ciències, Llegir científicament – 15/09/2016
El passat dia 15 de setembre de 2016, de 17.00 a 18.30h, en el marc de les Tertúlies de Literatura Científica (TLC -UVic) es va dur a terme la primera activitat de la 10a edició de [...]
1a Nit de la Biologia – 7/06/2016
La Societat Catalana de Biologia enguany ha obert la convocatòria d’un conjunt de cinc premis amb l’objectiu de distingir a les persones que més han contribuït al desenvolupament i a la difusió de les ciències [...]
Tríptic 10a Edició de les TLC
El projecte Tertúlies de Literatura Científica (TLC), és una proposta d’innovació docent dirigida a estudiants d’ensenyament secundari, batxillerat, cicles formatius i estudiants universitaris, amb la finalitat de promoure que els joves llegeixin llibres de divulgació científica [...]
Exposició: dibuixos naturalistes UVic-UCC
T'agrada dibuixar? T'agrada la natura? T'agrada dibuixar natura? No esperis més i participa en l'exposició de dibuixos naturalistes UVic-UCC! Es prepara per la SC/2016 - Biblioteca TF, UVic. Llegeix el cartell que hi ha a continuació:
Entrega de Premis de les Beques Fundació Espavila
Us convidem a l'entrega de Premis de les Beques Fundació Espavila http://www.espavila.cat/ Dia: 30 de juny de 2016 Hora: 19h Lloc: Aula Segimon Serrallonga de la UVic-UCC Inscripcions abans del dia 27 de juny de [...]
Sessió de treball de les TLC a la UVic -UCC
El passat dia 1 de juny de 2016 es va realitzar la sessió de treball de TLC i de PLLC a la UVic -UCC,per preparar les lectures a oferir pel curs 2016/17 Trobareu l'ACTA de la sessió de treball a http://mon.uvic.cat/tlc/que-son/equip-de-treball/reunions/ [...]
Idees curs 2016/17
Estem treballant ja en la 10a Edició de les TLC ( curs 2016/17). Ens ajudes? 💡 Diversos temes en: Alimentació, Biomedicina, transgènics, evolució… i sobretot molta Ciència…..! Durant les edicions de les Tertúlies de Literatura [...]
M.Pilar Gil – 4a Edició Premi Llegim Ciència – 24/02/16
En aquesta 4a edició del Premi Llegim Ciència s’ha decidit la lectura de la següent novel·la: Data entrega de premis Autor/a Novel·la Activitat 24 de febrer de 2016 M. Pilar Gil Brahe i Kepler, el [...]
Albert Bosch – Viure per sentir-se viu – Activitat realitzada el dia 16/02/16
Llibre: Viure per sentir-se viu Xerrada-debat: Viure per sentir-se viu El passat dia 16 de febrer de 2016, en el marc de les Tertúlies de Literatura Científica (TLC) es va dur a terme l’activitat “Viure per [...]
EXPOSICIÓ: La superació d’un matemàtic. Ferran Sunyer i Balaguer (1912 – 1967)
Ja es pot visitar l'exposició La superació d'un matemàtic: de l'1 de febrer – 27 març 2016 al Museu de l’Art de la Pell de Vic.
Toni Gabaldón – Menjant amb els nostres microbis – 16/12/15
Llibre: La digestión es la cuestión (De Giulia Enders) Xerrada-debat: Menjant amb els nostres microbis El passat dia 16 de desembre de 2015, en el marc de les Tertúlies de Literatura Científica (TLC) es va dur [...]
Exposició de papirobiologia – 2 de novembre al 4 de desembre – 2015
Exposició Papiro-Biologia: Una exposició de papiroflèxia a la facultat de ciències i tecnologia. A continuació podeu veure material interessant sobre l'exposició Papiro-Biologia: Cliqueu a Papiroflèxia i Un món de paper per més informació. A continuació [...]